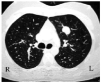
Tables

Introduction
The pulmonary inflammatory pseudotumor, first described in 1973,1 is a benign tumor of unidentified origin that appears in the literature under various names, such as post inflammatory tumor, histiocytoma, xanthoma, fibrous xanthoma, xanthogranuloma, plasma cell granuloma.
We describe our experience of 4 clinical cases that illustrate the tumor's diverse forms of presentation. In each case the pathologist's examination following surgical resection led to a firm diagnosis.
Case Descriptions
Case 1
The patient was male, 27 years of age, a smoker (1 pack-year), diagnosed with extrinsic bronchial asthma at the age of 4, under treatment with short acting β-2 agonists. He came to the emergency room complaining of nonspecific self-limited abdominal pain; a chest x-ray revealed a well-defined pulmonary nodule on the left upper lobe 2 centimeters in diameter showing apparent lobulation but no calcification. Physical examination, blood and urine analyses, and pulmonary functional tests revealed no abnormalities. Mantoux reaction at 72 hours was negative. Sputum culture bacteriology was negative for Ziehl-Neelsen and Löwenstein-Jensen stain protocols. A computed axial tomography (CT) scan confirmed the absence of adenopathy and added no findings to those detected by radiography. We performed a transbronchial biopsy, taking samples of the pulmonary parenchyma through the left bronchus, segment 2, with fresh bleeding. The biopsy results showed only chronic inflammation. Microbiology and cytology of bronchial brushings and aspiration yielded no conclusive findings.
Tests for the presence of tumor markers, including alpha-fetoprotein, human chorionic gonadotropin (HGC) and β-HGC, were negative. Presented with a pulmonary tumor of unidentified origin, we performed a diagnostic thoracotomy by atypical segmentectomy of the nodule on the left upper lobe and a lymphadenectomy of the diseased mediastinal nodes.
Pathology confirmed the presence of a lesion composed of spindle-shaped cells arranged in a whorled pattern with no atypia but occasional evidence of mitoses (1 to 2 per 10 high power fields). Scattered multinucleated giant cells, inflammatory elements, and foci of xanthoma were interspersed. The growth margins were compressed and resection was complete.
Immunohistochemical study showed proliferative cells positive for vimentin and α-actin, and negative for desmin, keratin, CD34, p53, and bcl-2. Proliferative activity by Ki67 expression was 18%. These findings corresponded to an inflammatory pseudotumor of the fibrohistiocytic type.
Case 2
The patient was a 22-year-old man of Ecuadorian origin who had been living in Spain for a year and a half and who had no relevant medical or surgical history and no toxic habits. He reported experiencing slight hemoptysis (10 mL/day) during the days prior to his hospitalization, with no dyspnea or associated constitutional syndrome. Exploration revealed pityriasis alba.
A chest x-ray showed a right-sided pericardial nodule and a small left perihilar infiltrate. A CT scan revealed a nodule adjacent to the wall of the right anterior indicative of inflammatory disease.
A simple blood test revealed only slight eosinophilia. A stool culture was requested and was negative, as was serology for human deficiency virus and toxoplasma. There was no hydatidosis. No tumor markers, including βHCG, were present.
No conclusive findings arose from either fiberoptic bronchoscopy or transthoracic fine-needle aspiration. We decided on video assisted thorascopic surgery (VATS) to resect the nodular lesion on the median lobe and to obtain a biopsy specimen of the pulmonary parenchyma adjacent to the median lobe.
Pathology confirmed the presence of a nodule with well-defined margins on the median lobe; it consisted of connective tissue with keloid-type hyalinization, slight lymphoplasmacytic infiltration of the lesion, presence of peripheral lymphoid follicles, and calcifications. Histochemical examination (Grocott methenamine silver, Giemsa, periodic acid-Schiff, and Congo red staining) gave no indication of granulomas, necrosis, or microorganisms. The clinical picture corresponded to pulmonary hyalinizing granuloma.
Case 3
The patient was male, 40 years of age, a smoker (10 pack-years). In the preoperative examination an ill-defined, nonhomogeneous nodule approximately 2 centimeters in diameter was detected on the right upper lobe; there were no accompanying symptoms. Physical status was normal upon examination and blood and tumor marker tests were negative. Spirometry presented values within normal ranges. A chest CT scan was requested and confirmed the presence of a very dense, 1.7-centimeter, nodular lesion with spiculated margins on the anterior segment of the right upper lobe making some contact with the axillary and parietal portion of the pleura and the visceral compartment of the mediastinum. No other lymph node or mediastinal involvement was visible; liver and suprarenal glands were normal. Fiberoptic bronchoscopy revealed acute generalized inflammation; bronchial brushings and biopsy were negative for malignancy. Transthoracic fine needle aspiration likewise gave no conclusive findings.
We decided to perform a diagnostic surgical procedure. An atypical resection of the tumor was performed by right posterolateral thoracotomy. The intraoperative diagnosis was fibrous nodule with no evidence of malignancy.
Pathology confirmed benign spindle-cell proliferation, consistent with a diagnosis of inflammatory pseudotumor. Visible microscopically was a well-defined proliferation of spindle cells arranged in sickle configuration and intermixed with large sickles of hyalinized collagen; also present were accumulations of predominantly lymphoplasmacytoid inflammatory cells. No mitotic activity was apparent. On the edges of the tumor we observed abundant bronchioloalveolar components. Immunohistochemical tests were positive for vimentin and, focally, for CD99 and α-actin, but negative for CD34. The diagnosis was inflammatory pseudotumor of the fibrohistiocytic type.
Case 4
The patient was male, 62 years of age, an active smoker (63 pack-years), and had no relevant medical history. Of note were 2 operations: one in 1993 for an atypical giant lipoma on his right thigh and one in 1995 for cutaneous leishmaniasis on his nose. The patient reported that for the 3 weeks prior to his hospitalization, he had experienced a cough with slight mucous expectoration, thoracic pressure that increased with respiratory movement but which was relieved by analgesia, various episodes of epistaxis, and occasional traces of blood in his sputum. During the year prior to hospitalization he had lost an undetermined amount of weight with no accompanying asthenia or anorexia. Physical examination and blood and coagulation analysis revealed no abnormalities. Spirometry indicated a slight obstructive ventilatory disfunction.
A chest x-ray showed an ill-defined consolidation with air bronchogram in the right upper zone, loss of right upper lobe volume, and an enlarged right hilum. A chest CT scan was performed in which a 5-centimeter mass with spiculated margins was visible on the right upper lung accompanied by a thickening of the adjacent pleura, affected mediastinal nodes of 1 and 1.5 centimeters in the peritracheal retrocaval space, and a solid 2.5-centimeter left adrenal nodule. With these data we proceeded to perform a suprarenal examination by a magnetic resonance image, which revealed a lesion highly indicative of adenoma. Sputum culture bacteriology was negative on Ziehl-Neelsen and Löwenstein-Jensen stain protocols. Fiberoptic bronchoscopy revealed signs of exacerbated chronic inflammation in the trachea and bronchial tree with no endobronchial lesions. Bronchial brushings, aspiration, and biopsy were negative for malignancy; bacteriology of the samples was also negative.
Three thoracic fine needle aspirations were performed to identify the origin of the lesion, the third leading to suspicion of inflammatory pseudotumor. Given these results we decided on surgical exploration of the thorax. By right posterolateral thoracotomy we resected 2 nodules from the lower right lobe and a giant tumor was seen to extend to the hilum, almost totally occupying the upper right lobe. We performed an upper right lobectomy according to usual practice as well as mediastinal lymphadenectomy. The pathologist described an ill-defined, 5-centimeter, nodular formation situated 3 centimeters from the bronchial surgical margin; the formation was composed of a fairly elastic, whitish-gray tissue containing blackish areas. The lesion corresponded to an inflammatory pseudotumor composed of inflammatory cells, macrophages, fibroblasts, and connective tissue arranged in storiform configuration. Vascular and epithelioid bronchioloalveolar elements were present inside the tumoral mass. Organized pneumonia and pachypleuritis were visible on the edges.
On the lower right lobe a chondroid hamartoma with perilesional organized pneumonia was visible and, after cutting the piece, 2 microscopic nodules (8 mm) were identified; these corresponded to an organized pneumonia and an inflammatory pseudotumor. Examination of the lymph nodes sent for study showed reactive hyperplasia with anthracosis.
Discussion
Pulmonary inflammatory pseudotumors are rare, accounting for 0.7% of pulmonary tumors2 and with no predilection for sex or race. More than half the patients with such tumors are under 40 years of age and 15% are between 1 and 10 years of age.3 The etiology and pathogenesis of pulmonary pseudotumors are unknown, although the presence of primary pulmonary infection has been described in a third of cases.
Pseudotumors involve a nonneoplastic process characterized by abnormal growth of inflammatory cells. Not confined to the lungs, they can grow in other organs such as the brain, gall bladder, stomach, retroperitoneum, kidney, meninges, and liver.4,5 Their diagnosis is a problem in any organ as they are such rare entities and biopsies of small samples reveal only inflammatory cells.
Macroscopically, they appear well defined but nonencapsulated, hard, and yellowish-white or grayish when sectioned. Most are found in the pulmonary parenchyma (Figure 1), but they can be endobronchial,2 causing obstruction. Fewer than 5% show invasion of the mediastinum or the thoracic wall.1
Figure 1. Chest CT scan showing a well-defined in traparenchymal pulmonary lesion. The postoperative diagnosis was inflammatory pseudotumor.
Microscopically (Figure 2), the lesions consist of variated mixtures of fibroblasts and granulation tissue, fibrous tissue, and inflammatory cells--including lymphocytes, histiocytes, giant cells, macrophages, eosinophilic neutrophils, and a great number of plasmatic cells.5-6
Figure 2. Microscopic view of an inflammatory pseudotumor. The pulmonary parenchyma is occupied by a fibrous area containing lymphoid follicles.
Immunohistochemical studies have revealed the polyclonal nature of the plasmatic cells, with immunoglobulin G predominance. Depending on the predominant cell type, inflammatory pseudotumors are classified in 3 groups: organized pneumonia with fibroblast predominance, fibrous histiocytoma, and lymphoplasmacytoma.7,8
Many patients are asymptomatic and the inflammatory pseudotumor is detected by chance in x-rays performed for other reasons, as occurred in half of the cases in the present report. However, the patient may present symptoms such as cough, hemoptysis, dyspnea, or chest pain.
Radiologically, the inflammatory pseudotumor is visible as a solitary pulmonary nodule or focus of consolidation that can imitate a primary or metastatic tumor. Occasionally calcification is present and, less frequently, cavitation. Endobronchial tumors can produce obstructive pneumonitis. The 4 cases in the present article were exclusively intraparenchymal, with no endobronchial involvement.
In a revision of 60 patients with inflammatory pseudotumors, 87% showed pseudotumors visible as nodules or solitary peripheral masses; 5%, as multiple nodules; and the rest, as mediastinal masses, endotracheal tumor in 1 case, endobronchial tumor, or clearly-defined pleural mass.9 The tumors were more than 3 centimeters in diameter in 31 patients; secondary involvement was observed through the opening of the airways as a parenchymal lesion in 6 patients and as lobular atelectasis in 5 patients. Hilar or mediastinal lymphadenopathy and pleural effusion were observed in a small number of cases.
During long-term follow up, no change in the size or configuration of these lesions has been observed, although some have grown over time, sometimes rapidly.1 In some patients for whom a diagnosis was established only by biopsy, lesion regression was reported following corticosteroid treatment or without such treatment10; however, other patients suffered recurrence after apparent complete surgical resection. Moreover, a small percentage of cases showed locally aggressive invasion of the pulmonary vessels, the thoracic wall, or the mediastinum.11 According to some authors, diagnosis by transbronchial or transthoracic needle biopsy often leads to confusing the pseudotumor with fibrohistiocytic neoplasia, Hodgkin's lymphoma, primary carcinoma of the lung, or mediastinal fibrosis, and are therefore considered unnecessary before surgery.12 Such authors propose complete resection of the lesion for diagnosis as well as for treatment.12 Further, they comment that wedge resection is appropriate if the resection is thereby complete; lobectomy is called for if total resection of the tumor is required, providing the functional capacity of the patient permits such treatment.12
Early and complete surgical resection of inflammatory pseudotumors is considered the best option for both ruling out malignancy and curing the patient. Postponing diagnosis and treatment can considerably increase the magnitude of the surgical intervention required.13 Among the diagnostic and therapeutic strategies used for solitary pulmonary nodules of undetermined origin, VATS is increasingly applied because the lesions can be easily excised to obtain a diagnosis and, if necessary, an oncological intervention can be performed in the same surgical event.
According to Congreado et al14 biopsy by VATS compared to biopsy by thoracotomy results in lower rates of morbidity and mortality; in their study VATS provided a diagnosis in 98.3% of the cases, 14 of which were inflammatory pseudotumor. We agree with Congreado et al and proceed to surgical treatment of patients clinically or pathologically suspected of inflammatory pseudotumor. Moreover, in the second case we report here, we were able to proceed with resection by VATS, given the size of the lesion and the fact that mediastinal lymphadenectomy, in this situation, is not recommended.
Alternative treatment to surgery, such as radiotherapy, chemotherapy, and corticosteroids,6 can play a part in cases of incomplete surgical resection, multifocal disease, postsurgical tumoral recurrence, or counter indications for pulmonary resection in an individual.13 In Case 4 a second inflammatory pseudotumor was found (microscopically) when the pathologist sectioned the excised tissue. Although the involvement of 2 or more organs (such as the brain or the liver) is described in the literature, in our series we found disseminated disease only in the aforementioned case, only in the intralobar zone.
The 4 patients described in this report presented no postoperative complications and were disease-free after 1 year.
In conclusion, inflammatory pseudotumor is a rare entity. It frequently occurs in children, can grow to a considerable size, and may be locally invasive, requiring major surgical resection. Surgical treatment of these lesions, whenever possible--whether by wedge resection, lobectomy, or pneumonectomy--leads to a firm diagnosis and an early cure. Complete resection of the lesion is safe and leads to high probability of survival.
Correspondence: Dr. C. Payá Llorens.
Avda. Pintor Xavier Soler, 7, torre D, 6.º A. 03015 Alicante. España.
E-mail: cecilia_paya@hotmail.com
Manuscript received March 3, 2003.
Accepted for publication April 8, 2003.